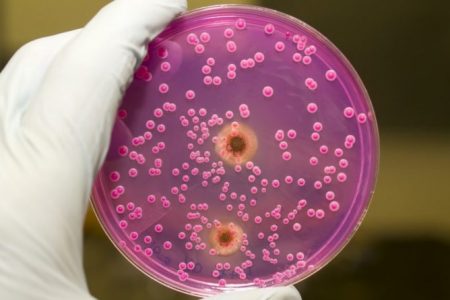

Мікоз в паховій області є одним з видів грибкових захворювань. …

ВСЕ ПРО МЕДИЦИНУ
Мікоз в паховій області є одним з видів грибкових захворювань. …

Одне з найпоширеніших, але все ж не рідкісних захворювань – …

Кандидоз зустрічається не тільки серед жінок, але й серед чоловіків. …

Короста – паразитарна хвороба, що виникає при попаданні під шкіру …

Геморой – проктологічне захворювання, яке характеризується варикозним розширенням вен у …

Масаж яєчок для підвищення тестостерону – це медична процедура, яка …

Лущення шкіри на голівці члена виникає приблизно у 40% чоловіків. …